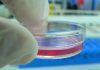
Polycistronic delivery of IL-10 and NT-3 to enhance spinal cord injury repair

TEHRAN – National projects worth 5 trillion rials (nearly $120 million at the official rate of 42,000 rials) were inaugurated nationwide in the field of pharmaceutical sciences, vaccines, and biotechnology on Thursday.
Projects in the fields of science, technology, and agriculture were launched in the provinces of Tehran, Alborz, and Markazi, which opened up 336 jobs.
“The opening of projects today is somewhat different in form, content, and importance. In fact, today’s openings mean the promotion of the country in science and technology, and this is very important for us,” President Hassan Rouhani said while inaugurating the projects through a video conference.
At present, plasma-derived medicinal products meet 30 percent of the country’s total need, but it will reach 100 percent within the next year, Sourena Sattari, vice president for the science and technology said for his part during the ceremony.
Referring to the launch of 82 medicinal products during the ceremony, he said that these plans will save a considerable currency, as the import of one of these medicines cost $27 million.
He went on to highlight that the import of pharmaceutical products needed for the production brought us a cost of $900 million, of which, $520 million is allocated to chemical drugs and $380 million is related to biomedicine, which today are produced.
The first production plan for plasma-based products, which was put into operation today, has the capacity to produce 150 million liters of blood products per year, and if supported, this amount will increase, he noted.
The plan saves €60 million annually for the country; currently, 160 people are directly employed, 70 percent of whom are young professionals, he emphasized.
The production of the “HPV” vaccine, or human papillomavirus, as one of the most effective vaccines in the prevention of uterine cancer in women, was another project inaugurated during the ceremony.
Sattari also told the Tehran Times in an exclusive interview that Iran is playing the leading role in the region in the fields of fintech, ICT, stem cell, aerospace, and is unrivaled in artificial intelligence.
Fortunately, last year, companies achieved a record sale of 1.2 quadrillion rials (nearly $28.5 billion), which is expected to increase by 40 percent this year.
To date, 42 knowledge-based companies with a total value of 2.8 quadrillion rials (nearly $66.6 billion) have been listed on the stock exchange and they will soon turn into the biggest businesses in the county,” he said.
Sattari said that U.S. sanctions caused exports of knowledge-based companies to decline three years ago, however, it has returned to growth and is projected to reach the pre-sanctions level of more than $1 billion by the end of the current [Iranian calendar] year (March 20, 2021).
Mehdi Kashmiri, director for technology and planning at the science ministry, said in July that about 450 knowledge-based companies were active in the country for manufacturing protective equipment and treatment products to fight the coronavirus.
Production of more than one million face masks per day, production of more than 1.5 liters of disinfectants per day, diagnostic kits, non-contact thermometers, protective clothing, ventilator are among the produces manufactured by these companies, he added.
Iranian-made innovative products in the field of diagnosis, screening, and fighting coronavirus were also unveiled to combat the disease, namely, ozone generator, nanotechnology face shields, disinfection gate, and molecular COVID-19 diagnostic kits.
FB/MG